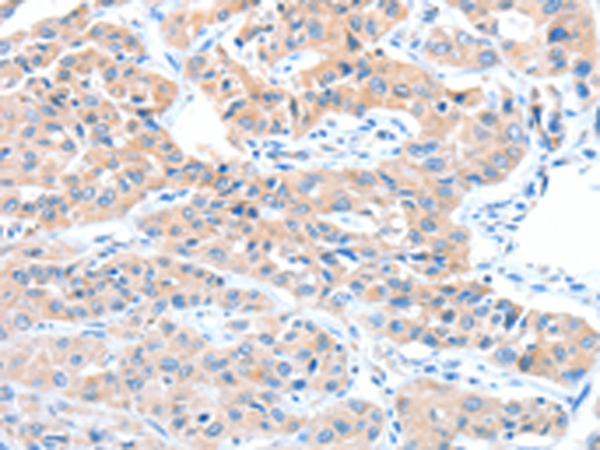

中文名稱: 兔抗ADAM32多克隆抗體
|
Background: |
A number of a disintegrin and metalloprotease (ADAM) family members are expressed in mammalian male reproductive organs such as testis and epididymis. The cDNA sequence of ADAM32 has an open reading frame which encodes 750 (mouse ADAM32) and 787 (human ADAM32) amino acids, sharing 69% homology between the two species. Comparison of amino acid sequences showed that ADAM32 is highly homologous to ADAM2 and ADAM3, sperm surface proteins required for fertilization. We found that the ADAM32 gene is expressed predominantly in the testis. |
|
Applications: |
ELISA, WB, IHC |
|
Name of antibody: |
ADAM32 |
|
Immunogen: |
Fusion protein of human ADAM32 |
|
Full name: |
ADAM metallopeptidase domain 32 |
|
SwissProt: |
Q8TC27 |
|
ELISA Recommended dilution: |
1000-2000 |
|
IHC positive control: |
Human lung cancer and Human breast cancer |
|
IHC Recommend dilution: |
15-50 |
|
WB Predicted band size: |
88 kDa |
|
WB Positive control: |
Human testis tissue |
|
WB Recommended dilution: |
200-1000 |

購物車
購物車 幫助
幫助
 021-54845833/15800441009
021-54845833/15800441009
